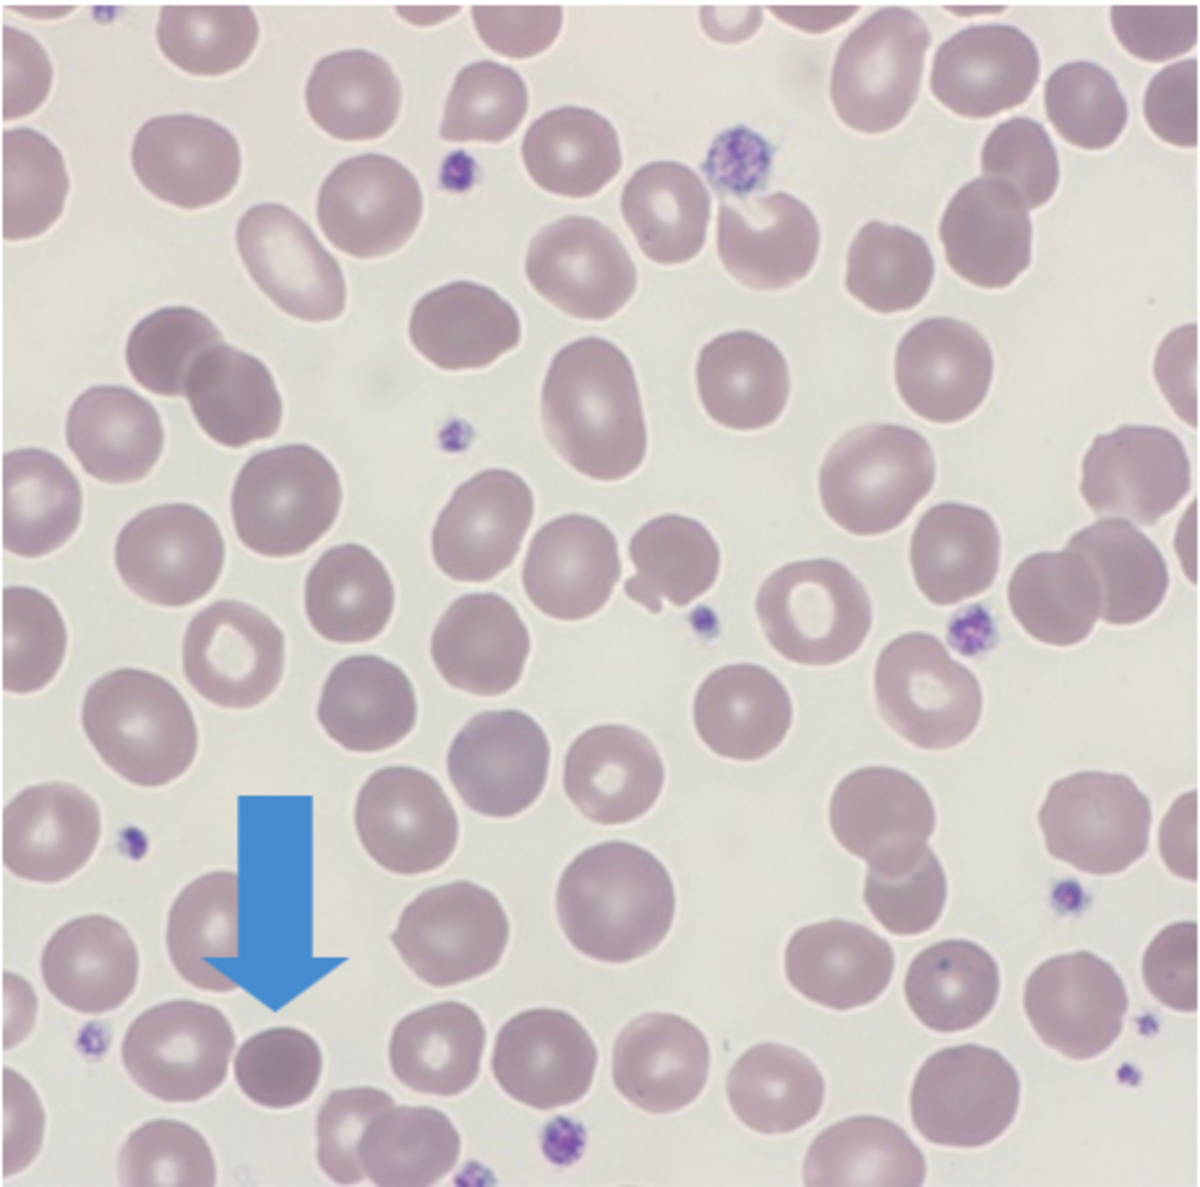
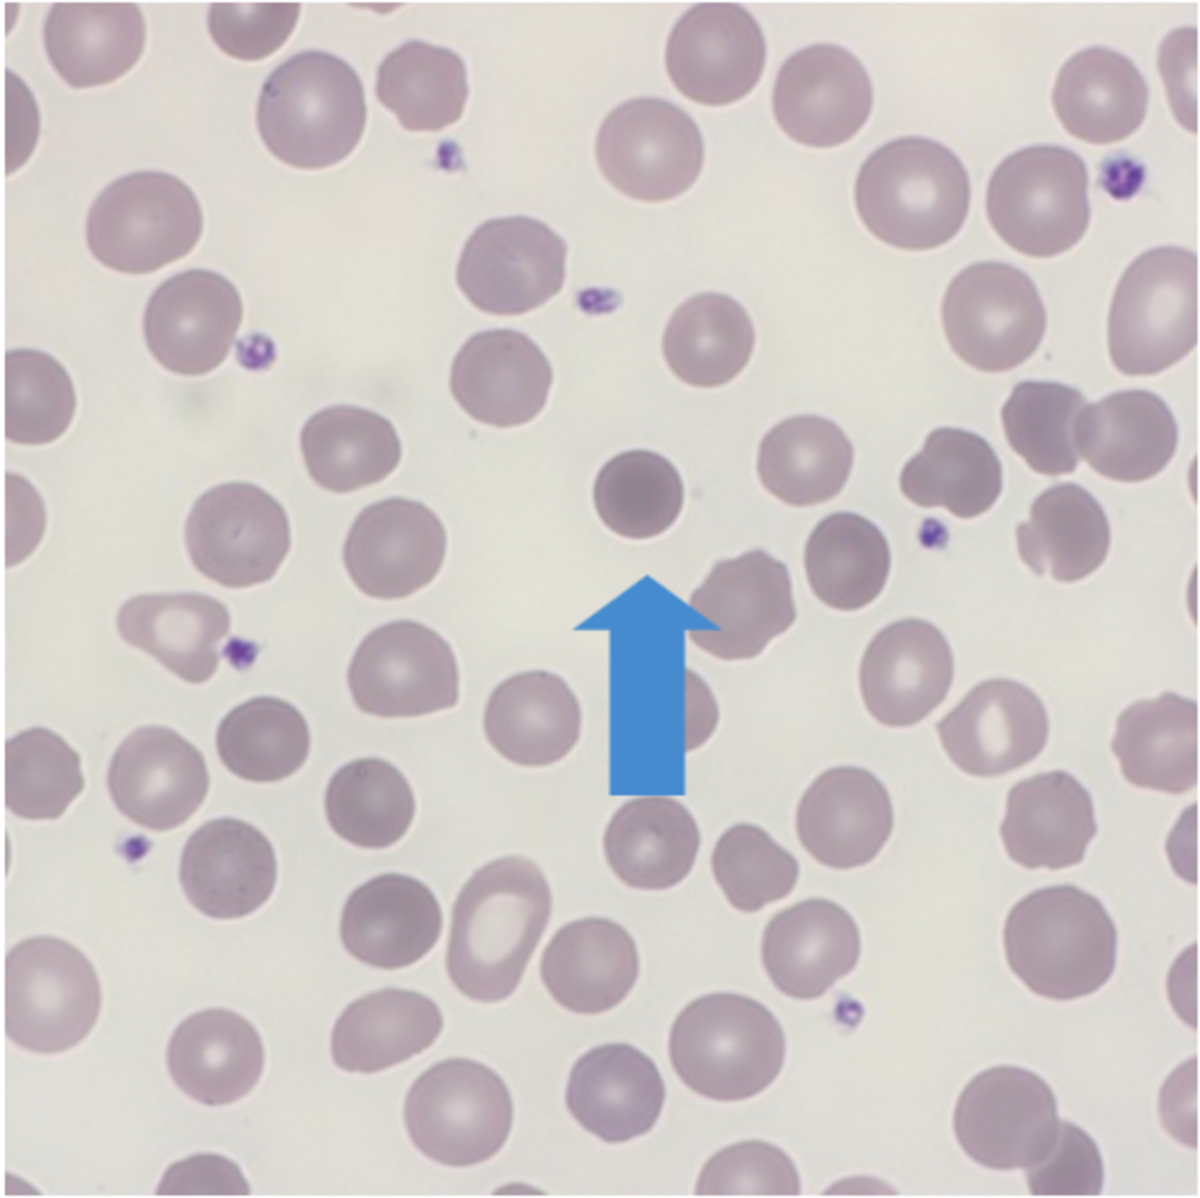
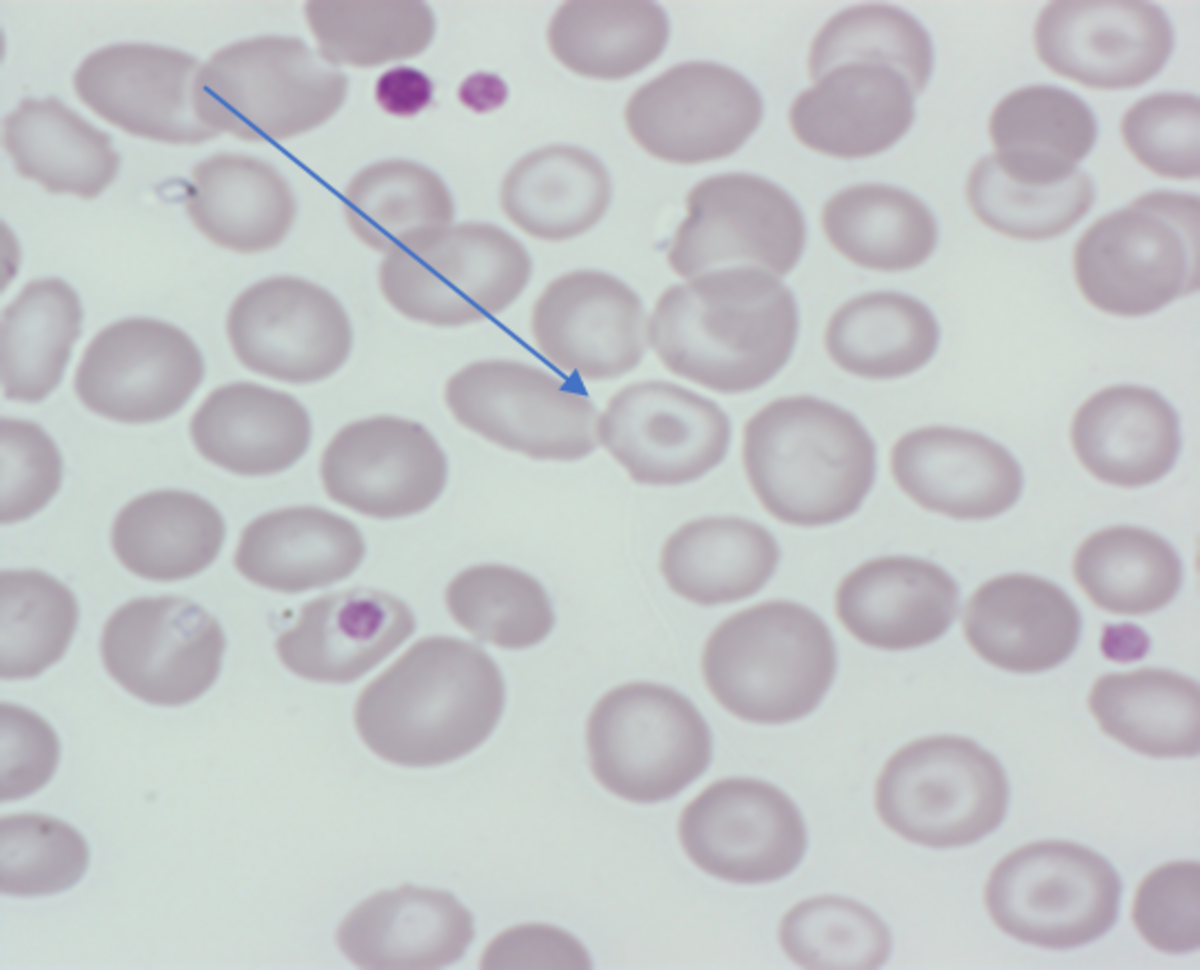

Subscribe now!

Subscribe and receive Heme Insights from the next issue.
Hereditary Spherocytosis (HS) is a heterogenous group of disorders characterized by the presence of Spherocytes. Clinical features may include anemia, jaundice, reticulocytosis and splenomegaly.
Female (45 years old)
| FBC | |
|---|---|
| WBC 5.5 (10^3/mm3) | MCV 91 (fL) |
| RBC 3.37 (10^6/mm3) | MCH 31.2 (pg) |
| HGB 10.5 (g/dL) | MCHC 34.4 (g/dL) |
| HCT 30.5 (%) | PLT 183 (10^3/mm3) |
Blue arrows showing spherocyte cells
Hereditary Spherocytosis (HS) was first described in 1871 and the first recorded splenectomy performed soon after. HS shows a wide range of features in regard to severity, mode of inheritance, and the actual cause of the protein defect. It is a relatively common disorder with an incidence in North Europe and North America of between 1 in 2,000 to 1 in 5,000 (depending on method of analysis). Affected patients will show a variable degree of anemia, jaundice, reticulocytosis, and splenomegaly with the clinical severity ranging from symptom free (carrier) to severe hemolysis. Exacerbation of clinical severity can be caused by illnesses such as Infectious Mononucleosis. The majority (75%) of cases will have a family history even if HS has not been formally diagnosed e.g., anemia, splenectomy, gall stones, jaundice. The diagnosis of HS has been made from birth all the way up to people in their 80’s-90’s, sometimes the diagnosis is made serendipitously. HS carriers may not show anemia, jaundice or splenomegaly and with no spherocytes seen on the blood smear.
Normal red cells are biconcave discs which have a large surface area to volume and have no nucleus allowing the red cell to contain relatively large amounts of hemoglobin. Red cells need to be flexible in order to travel through tiny capillaries so that they can absorb and deliver oxygen where needed. A disturbance in the cytoskeleton can have a profound effect on the flexibility and eventual life span of the red cell. Red cell membrane integrity is dependent upon several proteins with spectrin being one of the main contributors. Abnormal red cell morphology seen in HS is due to a specific genetic mutation leading to a deficiency of, or a dysfunction in spectrin, ankyrin, band 3 and or protein 4.2.
Spherocytic red cells are removed from circulation by the spleen resulting in splenomegaly and an increase in bilirubin.
Spherocytes can be distinguished from normal red cells by the uniform dense color of the cytoplasm and can be smaller than that of a normal red cell.
As described above, the clinical picture in HS is varied but if Spherocytes are seen in the blood smear, a Direct Antiglobulin test should be performed to exclude auto hemolysis. A reticulocyte count should also be performed to confirm the degree of excess red cell production.
A family history is essential in the correct diagnosis of HS with note being taken of family members who have had a splenectomy for no obvious reason or gall bladder problems.
Further tests such as Osmotic Fragility, Acidified Glycerol Lysis time (AGLT), Pink test (a modified AGLT) are all based on the fact that spherocytosis are more prone to lysis than normal red cells.
Folate therapy is recommended in children with moderate and severe HS. The patient should be offered a regular review particularly those with a moderate to severe form as splenectomy may be required.
Look at this slide, can you name the cell? What possible clinical details would this patient likely have? Choose from the options: A) Glandular fever B) Nothing abnormal C) Thalassemia
The Answer: Target cell, C) Thalassemia
Target cells are red blood cells that have the appearance of a shooting target with a bullseye. In optical microscopy, these cells appear to have a dark center (a central, hemoglobinized area) surrounded by a white ring (an area of relative pallor). Clinical details may include anemia-like symptoms with a reduced MCV.
Bibliography
Blood Cells A practical guide – Barbara Bain
Guidelines for the diagnosis and management of Hereditary Spherocytosis
A BMJ Guideline publication
https://onlinelibrary.wiley.com/doi/epdf/10.1111/j.1365-2141.2004.05052.x
Editorial Team
Kelly Duffy, Andrew Fisher, HORIBA UK Limited